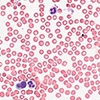
millipore_dyes_stains_100.jpg millipore_dyes_stains_100.jpg

Harleco & Midas - Made for Each Other
- Highest Quality Stain Solutions - IVD certified, also certified by the Biological Stain Commission
- Ready to use staining solutions for blood and bone marrow samples with intense and reproducible results
- Very clean results in less than 1 minute with Hemacolor®

The Midas® III-Plus Automated Stainer
- The six station unit holds 20 or 30 slides
- Up to 10 programs - each program can have up to 29 steps
- Save up to 50% on stain consumption vs. flood or spray techniques